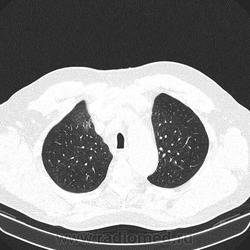
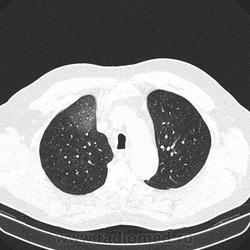
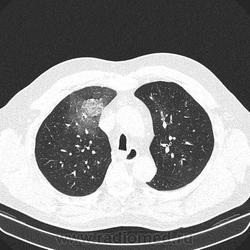
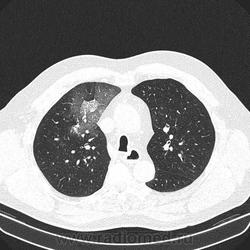
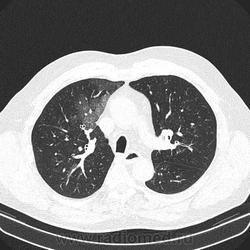
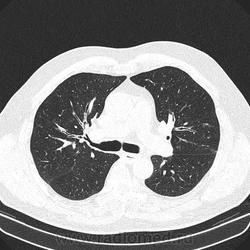
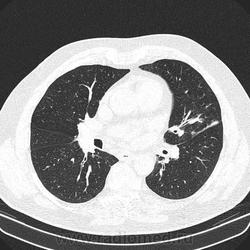
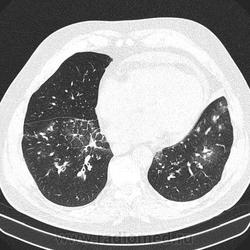
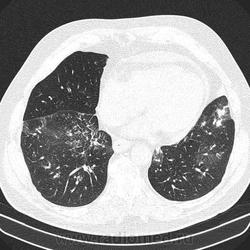

Пол пациента:
Тип патологии:
Область исследования:
Методы исследования:
- https://radiomed.ru/sites/default/files/styles/case_slider_image/public/user/16314/dd_1.ct_.0004.0104.2014.02.26.13.46.33.15625.150319102_8.jpeg?itok=EV4y4-pL
- https://radiomed.ru/sites/default/files/styles/case_slider_image/public/user/16314/dd_1.ct_.0004.0119.2014.02.26.13.46.33.15625.150319432.jpeg?itok=4G1TyIHN
- https://radiomed.ru/sites/default/files/styles/case_slider_image/public/user/16314/dd_1.ct_.0004.0126.2014.02.26.13.46.33.15625.150319586.jpeg?itok=cmEXFeV8
- https://radiomed.ru/sites/default/files/styles/case_slider_image/public/user/16314/dd_1.ct_.0004.0138.2014.02.26.13.46.33.15625.150319934.jpeg?itok=JqL-ySr8
- https://radiomed.ru/sites/default/files/styles/case_slider_image/public/user/16314/dd_1.ct_.0004.0150.2014.02.26.13.46.33.15625.150320198_29.jpeg?itok=Nul0pUSD
- https://radiomed.ru/sites/default/files/styles/case_slider_image/public/user/16314/dd_1.ct_.0004.0164.2014.02.26.13.46.33.15625.150320506_6.jpeg?itok=UlcfivsS
- https://radiomed.ru/sites/default/files/styles/case_slider_image/public/user/16314/dd_1.ct_.0004.0193.2014.02.26.13.46.33.15625.150321212.jpeg?itok=0eesRcR9
- https://radiomed.ru/sites/default/files/styles/case_slider_image/public/user/16314/dd_1.ct_.0004.0227.2014.02.26.13.46.33.15625.150322048.jpeg?itok=MRjv2eZB
- https://radiomed.ru/sites/default/files/styles/case_slider_image/public/user/16314/dd_1.ct_.0004.0282.2014.02.26.13.46.33.15625.150323340.jpeg?itok=TWV22jxo
- https://radiomed.ru/sites/default/files/styles/case_slider_image/public/user/16314/dd_1.ct_.0004.0389.2014.02.26.13.46.33.15625.150325932.jpeg?itok=NLOipttu
- https://radiomed.ru/sites/default/files/styles/case_slider_image/public/user/16314/dd_1.ct_.0004.0399.2014.02.26.13.46.33.15625.150326152.jpeg?itok=VUTpvTyg
- https://radiomed.ru/sites/default/files/styles/case_slider_image/public/user/16314/dd_1.ct_.0004.0405.2014.02.26.13.46.33.15625.150326284.jpeg?itok=b3TnBtmf
- https://radiomed.ru/sites/default/files/styles/case_slider_image/public/user/16314/dd_1.ct_.0004.0409.2014.02.26.13.46.33.15625.150326372.jpeg?itok=Scwp3HKf
ID:35815

Альвеолярное кровоизлияние.
https://www.youtube.com/channel/UCBGxoBUOqUT_bFhSeUgtWEw
хорошо бы с контрастом посмотреть. подозрений клинически на ТЭЛА не было?
"There is no teacher, who can teach us anything new. He just can help us to remember the things we always knew" (c) Enigma.
Как на счет туберкулеза?
+1. Надо искать причину.
Полисегментарная пневмония.
всем спасибо.
оказалось ТЭЛА.
эту пневмонию вылечили, через некоторое время пациент поступил с подобной картиной в другом легком.
потом нашли тромб в артериях н/конечностей.